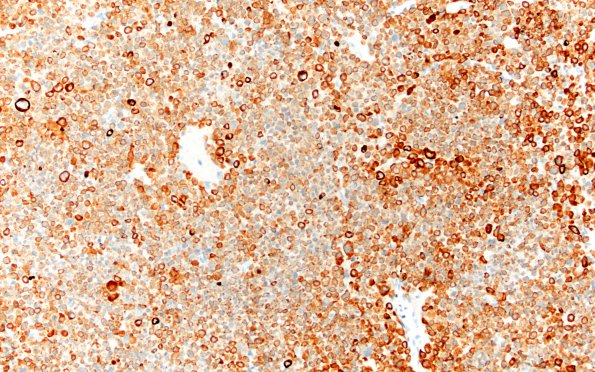
8C1 PA CR (Case 8) CK 20X

Table of Contents
Washington University Experience | NEOPLASM (SELLAR) | Pituitary Adenoma - Pituitary Neuroendocrine Neoplasm | Corticotroph | 8C1 PA CR (Case 8) CK 20X
8C1-4 Pan-cytokeratin (8C1,2) and CAM5.2 (8C3,4) show intense circumferential perinuclear staining in a subpopulation of tumor cells, confirming the presence of Crooke's hyaline in approximately 20% of the tumor cells. (CAM5.2 IHC)